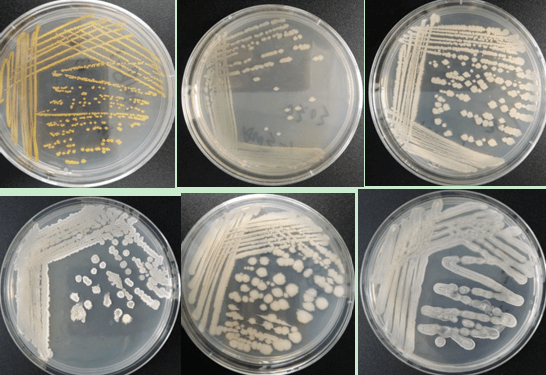
图2对样品中的微生物进行分离培养纯化汉和生物最新进展:运用可培养

微生物分离纯化

微生物的分离纯化ppt
图片尺寸1080x810
微生物的分离和纯培养ppt模板
图片尺寸1200x5355
产酸,耐酸乳酸菌的分离鉴定及益生特性
图片尺寸3150x1906
它们要分家详解微生物的分离纯化
图片尺寸584x381
它们要"分家":详解微生物的分离纯化!
图片尺寸312x287
图2对样品中的微生物进行分离培养纯化汉和生物最新进展:运用可培养
图片尺寸546x375
食品微生物实验技术--实验六稀释平板计数及霉菌,酵母菌的分离与鉴定
图片尺寸1080x810
微生物分离纯化及鉴定技术
图片尺寸698x287
分离纯化技术
图片尺寸420x324
实验十二土壤中产抗生素放线菌的分离纯化共3页
图片尺寸920x1302
干货微生物的分离纯化详解
图片尺寸700x395
微基生物微生物分离培养流程及目的介绍
图片尺寸629x242
它们要"分家":详解微生物的分离纯化!
图片尺寸464x251
实验十四土壤中微生物的分离与纯化.doc
图片尺寸792x1120
土壤中分解纤维素,尿素的微生物的分离
图片尺寸1500x1500
学习情境九微生物分离纯化与保藏技术.pdf 42页
图片尺寸972x729
微生物的分离纯化ppt
图片尺寸1080x810
第三周微生物分离纯化接种与培养技术ppt
图片尺寸1080x810
福建省漳州市2019-2020学年高三下学期3月在线质检理综生物试卷
图片尺寸379x293
图 1. 分离纯化过程培养获得的乳酸菌,进行16s rdna测序.
图片尺寸1061x571